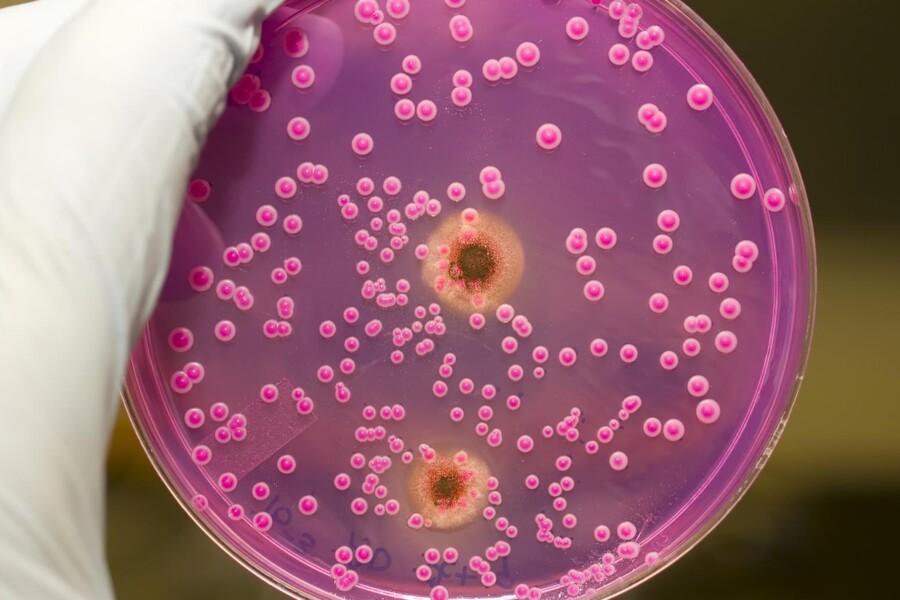
Moučnivka u dětí

Dehydratace je nedostatek tekutin v těle. Ohrožuje především děti a staré lidi.

Moučnivka u dětí je kvasinková infekce způsobená plísní Candida albicans. Toto nepříjemné onemocnění postihuje hlavně novorozence kojené i krmené z lahve a děti s poruchami imunitního systému nebo užívající antibiotika. Moučnivka se projevuje bílými nebo žlutavými skvrnami připomínající sražené mléko na jazyku, patře, dásních, rtech či v krku. Léčba moučnivky spočívá hlavně v užívání antimykotik, po kterých by infekce měla během několika dnů ustoupit.
Moučnivka je infekce způsobená kvasinkovou infekcí zvanou Candida albicans, která se nejčastěji vyskytuje v ústech novorozenců kojených i krmených z lahve. Postihuje také děti s nižší odolností vůči infekci způsobené nějakou jinou nemocí - například rakovinou - nebo děti, které užívají určitý druh antibiotik. Má-li matka v době porodu kvasinkovou infekci v pochvě, může se novorozenec nakazit moučnivkou během porodu při průchodu porodními cestami. Nákaza se může také přenést infikovanou savičkou kojenecké lahve nebo infikovaným matčiným prsem. Moučnivka je infekce kvasinkou, která je běžně v ústech přítomna, ale je pod kontrolou bakterií, které se v ústech vyskytují. Antibiotika se širokým spektrem tyto bakterie ničí a kvasinky se tak začnou nekontrolovatelně množit.
Dítěti se v ústech na jazyku, na patře, na dásních, na vnitřní straně tváří, na rtech a v krku vytvoří bílé nebo žlutavé skvrny, které připomínají sražené mléko a jdou obtížně setřít. Nejsou bolestivé, ale když se odstraní, vytvoří se pod nimi otevřené boláky.
Lékař obvykle určí diagnózu na základě prohlídky dítěte, někdy mu odebere vzorek skvrny k vyšetření pod mikroskopem. Léčba spočívá v užívání antimykotik, po kterých by infekce měla během několika dnů odeznít, může se však vrátit. Jestliže krmíte dítě z lahve, vyvarujte savičky před použitím alespoň 20 minut.